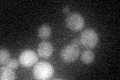
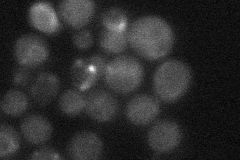
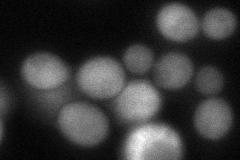
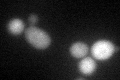
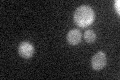

View description
Phosphoglucomutase, minor isoform; catalyzes the conversion from glucose-1-phosphate to glucose-6-phosphate, which is a key step in hexose metabolism
Localization:
Intensity:
Fold change:
Significance:
-
C’ GFP library in SD
cytosol29.67 -
N' NOP1pr-GFP in SD

cytosol250.345 -
N' TEF2pr-mCherry in SD

cytosol121.356 -
N' NATIVEpr-GFP in SD
cytosol22.8888 -
N' TEF2pr-VC and Cyto-VN in SD
cytosol81.7287 -
C’ GFP library in SD+DTT
cytosol31.651.06No -
C’ GFP library in SD+H2O2

cytosol35.041.18No -
C’ GFP library in Starvation Media
cytosol23.180.78No -
C’ GFP library on the background of Pup2-DaMP

N/A -
C’ GFP library on the background of CCT mutant

N/A0N/AYes
